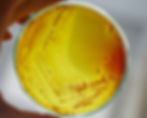
ree

Análise de bolores e leveduras no ar: importância, métodos e aplicações laboratoriais
- Enfermeira Natalia Balsalobre
- 1 de jul. de 2024
- 7 min de leitura
Introdução: o ar que respiramos e os microrganismos invisíveis
Quando pensamos na qualidade do ar, é comum associarmos o tema à presença de gases poluentes, partículas de poeira ou compostos químicos tóxicos.
No entanto, existe uma dimensão menos visível e igualmente relevante: o componente microbiológico do ar.
Entre os principais microrganismos presentes em ambientes atmosféricos estão os fungos filamentosos (bolores) e as leveduras — seres vivos microscópicos capazes de se dispersar amplamente e de se desenvolver em diferentes condições ambientais.
Esses microrganismos estão em todos os lugares: no solo, na água, nos alimentos, nas superfícies e, principalmente, suspensos no ar sob a forma de esporos.
A presença de bolores e leveduras em ambientes internos ou industriais pode indicar contaminação ambiental, afetar processos produtivos, alterar a qualidade de produtos e, em casos mais graves, representar risco à saúde humana.
A análise de bolores e leveduras no ar surge, portanto, como uma ferramenta essencial de monitoramento microbiológico ambiental, aplicada em indústrias alimentícias, farmacêuticas, hospitalares e de cosméticos, além de ambientes climatizados e áreas de manipulação sensíveis.
Neste artigo, exploraremos em profundidade como essa análise é conduzida, quais metodologias laboratoriais são empregadas, qual a importância dos resultados e como eles podem auxiliar empresas e instituições na manutenção da qualidade e da biossegurança ambiental.

O que são bolores e leveduras? Características e diferenças fundamentais
Os fungos constituem um grupo diversificado de organismos eucarióticos, heterotróficos e desprovidos de clorofila.
Dentro desse grupo, encontramos dois grandes tipos morfológicos predominantes: bolores e leveduras.
Bolores
Os bolores são fungos filamentosos multicelulares, que crescem formando estruturas conhecidas como hifas.
O conjunto dessas hifas constitui o micélio, responsável pela colonização de superfícies e pela liberação de esporos — partículas reprodutivas leves e resistentes que se dispersam facilmente pelo ar.
Os bolores podem ser encontrados em praticamente qualquer substrato orgânico: alimentos, tecidos, papel, madeira e até em materiais de construção.
Muitas espécies são responsáveis por decomposição natural, mas outras podem causar contaminação em produtos industrializados ou alergias respiratórias em humanos.
Exemplos comuns incluem:
Aspergillus spp.
Penicillium spp.
Cladosporium spp.
Fusarium spp.
Leveduras
As leveduras, por sua vez, são fungos unicelulares, com formato geralmente ovalado, que se reproduzem por brotamento ou fissão binária.
Embora muitas espécies de leveduras sejam utilizadas em processos benéficos — como na fermentação alcoólica e panificação —, algumas podem estar associadas à contaminação microbiológica em ambientes e produtos.
Espécies do gênero Candida, por exemplo, são frequentemente isoladas em análises ambientais, especialmente em locais com alta umidade e presença de matéria orgânica.
Em ambientes climatizados, as leveduras podem se desenvolver em filtros de ar e umidificadores, tornando-se potenciais fontes de contaminação.
Por que monitorar bolores e leveduras no ar?
A presença de fungos aerotransportados não é apenas um indicador ambiental, mas também um parâmetro de segurança sanitária.
Dependendo do ambiente, a avaliação da carga fúngica pode ter finalidades distintas.
Ambientes industriais e laboratoriais
Em setores como o alimentício, farmacêutico, cosmético e hospitalar, o controle microbiológico do ar é um requisito de Boas Práticas de Fabricação (BPF) e Boas Práticas de Laboratório (BPL).
A contaminação aérea por bolores e leveduras pode comprometer a qualidade de produtos sensíveis, causar perdas econômicas e gerar não conformidades regulatórias em auditorias.
Por exemplo:
Em indústrias de laticínios e panificação, a presença de esporos de Aspergillus e Penicillium pode levar à deterioração precoce dos produtos.
Em fábricas farmacêuticas, fungos ambientais podem contaminar salas limpas, interferindo na esterilidade de medicamentos e cosméticos.
Ambientes hospitalares e de saúde
Hospitais, laboratórios clínicos e salas cirúrgicas devem manter níveis mínimos de contaminação microbiológica do ar, pois pacientes imunocomprometidos podem desenvolver infecções fúngicas oportunistas.
O gênero Aspergillus, em especial, é conhecido por causar aspergilose, uma condição grave em pessoas com defesas imunológicas reduzidas.
Ambientes climatizados e públicos
O monitoramento também é relevante em escritórios, escolas, academias e residências com ar-condicionado.
A Resolução nº 9/2003 da ANVISA recomenda a avaliação periódica da qualidade do ar interior, incluindo parâmetros microbiológicos.
A presença excessiva de bolores e leveduras nesses sistemas pode causar síndromes respiratórias, reações alérgicas e mau odor ambiental.
Como é feita a análise de bolores e leveduras no ar
A análise microbiológica do ar pode ser conduzida por diferentes métodos, dependendo do objetivo, da sensibilidade desejada e da infraestrutura laboratorial disponível.
De forma geral, os métodos dividem-se em ativos e passivos.
Método passivo (placas de sedimentação)
É o método mais simples e amplamente utilizado.
Consiste na exposição de placas de Petri contendo meio de cultura seletivo (geralmente Ágar Sabouraud Dextrose) durante um período determinado, normalmente de 15 a 60 minutos.
Os esporos e células fúngicas presentes no ar sedimentam por gravidade sobre o meio e, após incubação, formam colônias visíveis.
Vantagens:
Simples e de baixo custo.
Não requer equipamentos especializados.
Fornece uma estimativa qualitativa da contaminação ambiental.
Limitações:
Não mede volume exato de ar analisado.
Menos sensível para detecção de concentrações muito baixas.
Método ativo (amostragem volumétrica de ar)
Neste método, o ar é aspirado mecanicamente através de um equipamento denominado amostrador de ar microbiológico (como impactadores ou impingers).
O ar é direcionado para uma superfície de meio de cultura ou solução de coleta, permitindo o cálculo da concentração de unidades formadoras de colônia (UFC) por metro cúbico de ar (UFC/m³).
Vantagens:
Resultados quantitativos e reprodutíveis.
Maior precisão em ambientes controlados (salas limpas, áreas ISO).
Cumpre normas específicas de controle ambiental.
Limitações:
Custo mais elevado.
Requer calibração e manutenção periódica dos equipamentos.
Meios de cultura utilizados
Os meios mais comuns incluem:
Ágar Sabouraud Dextrose (SDA): amplamente utilizado para isolamento de fungos e leveduras.
Ágar Potato Dextrose (PDA): favorece o crescimento de bolores filamentosos.
Ágar Malt Extract (MEA): utilizado para contagem de fungos ambientais em geral.
Incubação e leitura dos resultados
Após a coleta, as placas são incubadas em estufas a temperaturas entre 25 °C e 28 °C, por um período de 5 a 7 dias.
As colônias fúngicas são então contadas e identificadas macroscopicamente (cor, textura, morfologia) e, quando necessário, por microscopia ou técnicas moleculares (como PCR e sequenciamento de DNA).
Os resultados são expressos em UFC/m³ de ar (método ativo) ou em UFC/placa (método passivo), podendo ser comparados com limites recomendados em normas ou guias técnicos.
Interpretação dos resultados e ações corretivas
A interpretação depende do tipo de ambiente monitorado.
De modo geral, valores mais elevados de contagem fúngica indicam necessidade de intervenção imediata, como limpeza, desinfecção ou revisão dos sistemas de climatização.
Alguns referenciais:
Ambientes hospitalares críticos: ≤ 10 UFC/m³
Ambientes industriais limpos: ≤ 100 UFC/m³
Ambientes administrativos ou públicos: até 750 UFC/m³ podem ser aceitáveis, desde que não predominem espécies patogênicas
Quando são detectadas espécies de Aspergillus, Cladosporium, Alternaria ou Fusarium, recomenda-se investigação da fonte de contaminação (umidade, infiltração, filtros sujos etc.) e realização de nova coleta após a correção.
Aplicações práticas e exigências normativas
A análise de bolores e leveduras no ar é reconhecida por órgãos regulatórios nacionais e internacionais como parte das Boas Práticas de Fabricação e Controle Ambiental.
Entre as normas e guias de referência, destacam-se:
ANVISA – RDC 301/2019: Boas Práticas de Fabricação de medicamentos.
RE 09/2003 (ANVISA): Padrões referenciais de qualidade do ar interior.
ISO 14698-1 e 2: Controle de contaminação em ambientes controlados.
Farmacopeia Brasileira e Europeia: Métodos microbiológicos ambientais.
Além da conformidade regulatória, os dados de monitoramento auxiliam empresas a:
Avaliar a eficiência de sistemas de filtração e ventilação;
Identificar pontos críticos de contaminação;
Validar protocolos de limpeza e desinfecção;
Demonstrar segurança e rastreabilidade microbiológica em auditorias.
Tecnologias e avanços em detecção fúngica
Nos últimos anos, os métodos tradicionais de cultivo têm sido complementados por técnicas rápidas e sensíveis, como:
qPCR (reação em cadeia da polimerase quantitativa): detecta DNA fúngico em amostras de ar, mesmo quando os microrganismos não estão viáveis.
Biossensores ópticos e eletroquímicos: identificam presença de esporos em tempo real.
Análise metagenômica: permite mapear toda a microbiota presente no ar, oferecendo uma visão abrangente da biodiversidade fúngica.
Essas tecnologias têm ampliado o escopo da análise, permitindo o diagnóstico precoce de contaminações e a tomada de decisões rápidas em ambientes críticos.
Como o laboratório realiza a análise de bolores e leveduras no ar
Nosso laboratório realiza a análise de bolores e leveduras no ar seguindo rigorosos padrões de qualidade e rastreabilidade.
O processo inclui:
1. Planejamento da amostragem conforme a natureza do ambiente (industrial, hospitalar ou comercial).
2. Coleta ativa ou passiva com equipamentos calibrados e meios de cultura padronizados.
3. Incubação e leitura microbiológica sob condições controladas.
4. Identificação morfológica e microscópica das colônias.
5. Emissão de laudo técnico com interpretação e recomendações.
Os resultados são entregues em formato técnico-acadêmico, com todos os parâmetros necessários para auditorias, certificações e ações corretivas.
Conclusão
A análise de bolores e leveduras no ar é um procedimento indispensável para garantir a qualidade do ar e a biossegurança de ambientes internos e produtivos.
Mais do que uma exigência regulatória, trata-se de uma ferramenta preventiva, que auxilia na identificação precoce de contaminações, evita perdas econômicas e protege a saúde humana.
Empresas e instituições que realizam esse monitoramento periodicamente demonstram comprometimento com a segurança, a conformidade e a sustentabilidade ambiental — valores essenciais para a credibilidade de qualquer operação técnica ou industrial.
A Importância de Escolher o Lab2bio
Com anos de experiência no mercado, o Lab2bio possui um histórico comprovado de sucesso em análises laboratoriais.
Empresas do setor alimentício, indústrias farmacêuticas, laboratórios e outros segmentos confiam no Lab2bio para garantir a segurança e qualidade da água utilizada em suas atividades.
Evitar riscos de contaminação é um compromisso com a saúde de seus clientes e com a longevidade do seu negócio. Investir em análises periódicas é um diferencial que fortalece sua reputação e evita prejuízos futuro.
Para saber mais sobre Análise microbiológica de ar em ambientes climatizados artificialmente com o laboratório LAB2BIO - Análises de Ar e Água ligue para (11)91138-3253 ou (11) 2443-3786 ou clique aqui e solicite seu orçamento.
FAQ – Perguntas Frequentes
1. Qual é a frequência ideal para realizar a análise de bolores e leveduras no ar?
Depende do tipo de ambiente. Em áreas industriais ou laboratoriais, recomenda-se realizar mensalmente ou a cada novo ciclo de limpeza. Em ambientes comuns, a cada seis meses pode ser suficiente.
2. A análise pode detectar fungos patogênicos?
Sim. A identificação pode indicar a presença de gêneros potencialmente patogênicos, como Aspergillus, Fusarium ou Candida, auxiliando em medidas preventivas de saúde.
3. O teste pode ser feito em locais com ar-condicionado?
Sim. Ambientes climatizados são frequentemente avaliados, especialmente filtros, dutos e evaporadoras.
4. A coleta interfere nas atividades do ambiente?
Não. O procedimento é rápido, silencioso e não gera resíduos tóxicos.
5. Por que escolher um laboratório acreditado?
Laboratórios acreditados seguem normas rigorosas de qualidade, garantindo rastreabilidade, confiabilidade e validade técnica dos resultados.

